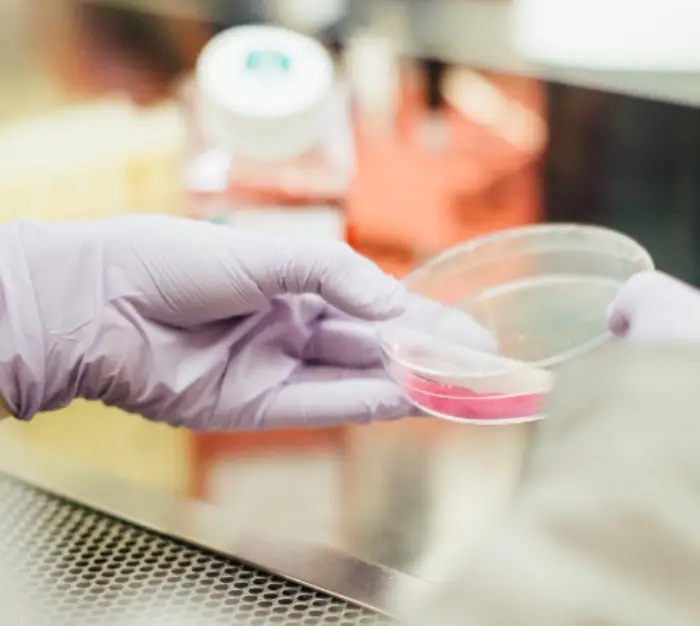
남자 헤르페스 2형

헤르페스 바이러스 보균자의 면역력이 떨어지면 체내 바이러스가 활동하기 시작하고 증상이 두드러집니다. 헤르페스 증상 부위에 따라 헤르페스 1형과 2형으로 구분됩니다. 여자와 남자 헤르페스 2형 증상과 잠복기, 전염, 완치 기간에 대해 살펴보겠습니다.
헤르페스 2형 증상

헤르페스 바이러스는 병변 부위에 따라 1형과 2형으로 나뉩니다. 헤르페스 1형은 주로 입술 주변으로 포진이 발생합니다. 주로 스트레스 , 환절기, 피로 누적 등 신체 면역력이 떨어지는 경우 흔히 발생합니다.
헤르페스 2형 바이러스는 남자, 여자 모두 감염될 수 있습니다. 헤르페스 2형의 경우 생식기와 항문 주변에 포진, 물집, 수포 등이 발생하기 때문에 생식기 헤르페스라고도 불립니다.
헤르페스 단순바이러스 2형 (HSV-2)에 의해 발생되며 감염의 주요 원인이 성접촉이 많아 헤르페스 2형 성병으로 분류되기도 합니다.
남자 헤르페스 2형 증상
남자 헤르페스 2형의 경우 음부가 따끔거리고 가려운 증상을 보이며 수포가 발생합니다. 수포는 한두개에서 여러 개가 군집하는 양상을 보이기도 합니다.
4-5일 지나면 수포가 터지게 되는데 이때 심한 통증을 동반하기도 합니다.
남자 헤르페스 2형 증상
- 가려움증
- 수포와 상처
- 배뇨 시 통증
- 발진



증상이 있는 경우 항바이러스제를 사용하여 바이러스 활동을 억제하고 증상을 완화할 수 있습니다. 가벼운 발진의 경우 아시클로버 연고와 같은 헤르페스 연고만으로 증상이 완화될 수도 있습니다.
여자 헤르페스 2형 증상
여자 헤르페스 2형의 경우 증상이 더 두드러지기 때문에 힘들어 하는 경우가 많습니다. 주로 사타구니 부근 주변을 따라 외음부에 숨어 있습니다
여자 헤르페스 2형 증상
- 수포
- 발진
- 배뇨시 통증 및 불편감
- 생식기 부위 통증
- 가려움증
여성의 생식기는 안으로 들어가는 구조이기 때문에 배뇨 시 통증이 크게 나타나는 것이 특징입니다. 수포가 20~30개씩 많이 발생하는 경우 살이 까지고 심한 통증을 동반합니다.
여자 헤르페스 2형은 연고 처방보다는 항생제를 복용하여 치료하는 경우가 많습니다.
헤르페스 2형 전염
헤르페스 바이러스는 손상된 피부 점막에 침투하여 감염을 일으키며 주변 신경 세포로 침투하는 양상을 보입니다. 헤르페스 2형 전염력이 가장 강한 시기는 수포 증상이 있을 때입니다.
수포가 잡히고 터지는 상황에서 헤르페스 2형 전염 확률이 가장 높습니다. 헤르페스 2형 전염은 수포가 보이지 않는 무증상 기간에도 50% 감염된다는 보고도 전해집니다.

임신기간 중 헤르페스에 감염이 되면 태아에게 전염될 가능성이 매우 높습니다. 간혹 출산 시 헤르페스 증상이 있는 경우 자연분만을 권하지 않는 경우도 있습니다.
헤르페스 2형 완치
헤르페스는 완치되지 않고 반복적으로 재발 가능성이 있는 질병입니다. 하지만 헤르페스 자체가 치명적인 질병이 아니니 크게 걱정할 필요는 없습니다.
헤르페스 바이러스에 노출된 후 이틀에서 일주일 정도 헤르페스 2형 잠복기를 거쳐 증상이 나타나기 시작합니다. 헤르페스 2형 잠복기는 길게는 수개월에서 수년까지도 걸리기도 하며 무증상으로 지낼 수 도 있습니다.



헤르페스 2형 재발은 일 년 기준 4~5회 정도로 보고된 바 있으며 헤르페스 2형 치료 기간은 발병 후 일주일에서 2주 정도입니다.
한번 헤르페스 2형 증상이 나타난 경우 면역력이 떨어질 때마다 반복해서 발생하게 됩니다. 하지만 재발 빈도가 높더라도 면역력 관리에 힘쓰면 감염되더라도 무증상이거나 가벼운 증상으로 넘어갈 수 있으니 건강관리에 힘쓰는 것이 중요합니다.
헤르페스 2형 검사
헤르페스 2형 간염이 의심되는 경우 전문적인 검사를 실시해보는 것도 방법입니다. 헤르페스 2형 검사 방법으로는 유전자증폭검사, 혈액검사, 항체검사 등이 있습니다.



위에서 언급한 바와 같이 헤르페스 2형 완치는 어렵기 때문에 검사를 진행하는 것이 효용성은 떨어집니다. 헤르페스 2형 증상이 나타났을 때 항바이러스 치료제를 빨리 복용하여 치료에 집중하는 것이 현명할 수 있습니다.
가장 빠른 헤르페스 치료 방법은 헤르페스 2형의 증상이 조금이라도 나타났을 때 적극적으로 치료하는 것이 중요합니다. 감염 정도는 개인에 따라 다양하게 나타날 수 있으니 증상이 의심되는 경우 전문가와 상담해야 합니다.
이와 함께 과음, 과로는 피하고 규칙적인 식습관, 꾸준한 운동, 충분한 휴식등 기본 건강관리 습관을 실천하시기 바랍니다
.
함께 보면 좋은 글
'건강' 카테고리의 다른 글
| 파상풍 주사 가격 초기증상 예방접종 기간과 비용 실비 확인하세요 (0) | 2023.10.31 |
|---|---|
| 청년신체건강증진서비스 신청 방법 지원금 대상자 바우처 받고 개인 맞춤지도 받으세요 (0) | 2023.10.19 |
| 헤르페스 1형 전염 증상에 아시클로버 연고 입술 헤르페스 크림 빨리 바르면 치료 빨라요 (0) | 2023.10.18 |